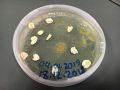
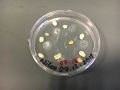

First Experience of Physarum with Medium of Ager
- Medium: 23.10.2018
- 100 ml of distilled water
- 2g of agar
- oat flakes
I made a new sample with a new medium. Parallel to the samples that I use for the experiment I started to use this new Medium to grow the specimen.
- Medium: 13.11.2018
- 100ml of distilled water
- 3g of agar
- oat flakes
- Medium: 04.12.2018
- 100 ml of distilled water
- 1g of agar
- Edible Color
- oat flakes
- Medium: 18.12.2018, Medium of my Project: [1]
- 100 ml of distilled water
- 2g of agar
- oat flakes